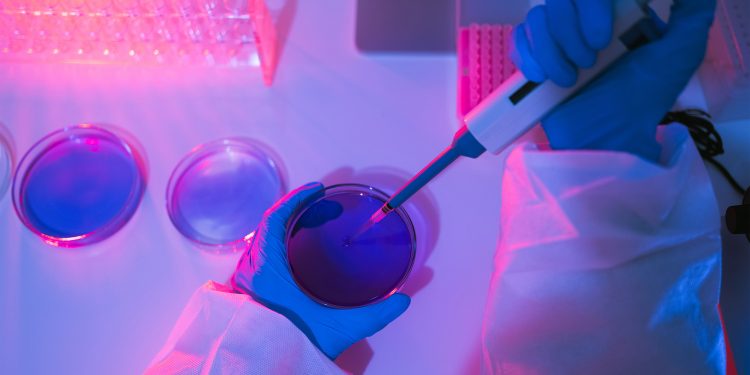
Beyond Ivy League, RFK Jr.’s NIH Slashed Science Funding Across States That Backed Trump

The Nationwide Institutes of Well being’s sweeping cuts of grants that fund scientific analysis are inflicting ache nearly universally throughout the U.S., together with in most states that backed President Donald Trump within the 2024 election.
A KFF Well being Information evaluation underscores that the terminations are sparing no a part of the nation, politically or geographically. About 40% of organizations whose grants the NIH lower in its first month of slashing, which began Feb. 28, are in states Trump gained in November.
The Trump administration has singled out Ivy League universities together with Columbia and Harvard for broad federal funding cuts. However the spending reductions on the NIH, the nation’s foremost supply of funding for biomedical analysis, go a lot additional: Of about 220 organizations that had grants terminated, at the least 94 have been public universities, together with flagship state colleges in locations reminiscent of Florida, Georgia, Ohio, Nebraska, and Texas.
The Trump administration has canceled tons of of grants supporting analysis on subjects reminiscent of vaccination; range, fairness, and inclusion; and the well being of LGBTQ+ populations. A few of the terminations are a results of Trump’s govt orders to desert federal work on range and fairness points. Others adopted the Senate affirmation of anti-vaccine activist Robert F. Kennedy Jr. to guide the Division of Well being and Human Providers, which oversees the NIH. Many mirror the ambitions specified by Mission 2025’s “Mandate for Management,” the conservative playbook for Trump’s second time period.
Affected researchers say Trump administration officers are taking a cudgel to efforts to enhance the lives of people that usually expertise worse well being outcomes — ignoring a scientific actuality that ailments and different situations don’t have an effect on all Individuals equally.
KFF Well being Information discovered that the NIH terminated about 780 grants or elements of grants between Feb. 28 and March 28, based on documents printed by the Division of Well being and Human Providers and a list maintained by academic researchers. Some grants have been canceled in full, whereas in different circumstances, solely dietary supplements — additional funding associated to the primary grant, normally for a shorter-term, associated mission — have been terminated.
Amongst U.S. recipients, 96 of the establishments that misplaced grants within the first month are in politically conservative states together with Florida, Ohio, and Indiana, the place Republicans management the state authorities or voters reliably help the GOP in presidential campaigns, or in purple states reminiscent of North Carolina, Michigan, and Pennsylvania that have been presidential battleground states. An extra 124 establishments are in blue states.
Sybil Hosek, a analysis professor on the College of Illinois-Chicago, helps run a community that focuses on bettering take care of individuals 13 to 24 years outdated who’re dwelling with or in danger for HIV. The NIH awarded Florida State University $73 million to guide the HIV mission.
“We by no means thought they’d destroy a complete community devoted to younger Individuals,” stated Hosek, one of many principal investigators of the Adolescent Medication Trials Community for HIV/AIDS Interventions. The termination “doesn’t make sense to us.”
NIH official Michelle Bulls is director of the Workplace of Coverage for Extramural Analysis Administration, which oversees grants coverage and compliance throughout NIH institutes. In terminating the grant March 21, Bulls wrote that analysis “primarily based totally on synthetic and nonscientific classes, together with amorphous fairness aims, are antithetical to the scientific inquiry, do nothing to develop our data of dwelling programs, present low returns on funding, and in the end don’t improve well being, lengthen life, or scale back sickness.”
Adolescents and younger adults ages 13 to 24 accounted for 1 in 5 new HIV infections within the U.S. in 2022, in line with the Facilities for Illness Management and Prevention.
“It’s science in its highest type,” stated Lisa Hightow-Weidman, a professor at Florida State College who co-leads the community. “I don’t assume we will make America wholesome once more if we go away youth behind.”
HHS spokesperson Emily Hilliard stated in an emailed assertion that “NIH is taking motion to terminate analysis funding that’s not aligned with NIH and HHS priorities.” The NIH and the White Home didn’t reply to requests for remark.
“As we start to Make America Wholesome Once more, it is vital to prioritize analysis that instantly impacts the well being of Individuals. We are going to go away no stone unturned in figuring out the basis causes of the persistent illness epidemic as a part of our mission to Make America Wholesome Once more,” Hilliard stated.
Hurt to HIV, Vaccine Research
The NIH, with its almost $48 billion annual funds, is the most important public funder of biomedical analysis on this planet, awarding almost 59,000 grants within the 2023 fiscal 12 months. The Trump administration has upended funding for tasks that have been already underway, stymied cash for brand spanking new purposes, and sought to scale back how a lot recipients can spend on overhead bills.
These modifications — plus the firing of 1,200 company workers as a part of mass layoffs throughout the federal government — are alarming scientists and NIH staff, who warn that they’ll undermine progress in combating ailments and different threats to the nation’s public well being. On April 2, the American Public Well being Affiliation, Ibis Reproductive Well being, and affected researchers, amongst others, filed a lawsuit in federal court docket in opposition to the NIH and HHS to halt the grant cancellations.
Two Nationwide Most cancers Institute workers, who have been granted anonymity as a result of they weren’t approved to talk to the press and feared retaliation, stated its workers receives batches of grants to terminate nearly every day. On Feb. 27, the most cancers institute had greater than 10,800 energetic tasks, the best share of the NIH’s roughly two dozen institutes and facilities, in line with the NIH’s web site. No less than 47 grants that NCI awarded have been terminated within the first month.
Kennedy has stated the NIH ought to take a years-long pause from funding infectious illness analysis. In November 2023, he instructed an anti-vaccine group, “I’m gonna say to NIH scientists, ‘God bless you all. Thanks for public service. We’re going to provide infectious illness a break for about eight years,’” according to NBC News.
For years, Kennedy has peddled falsehoods about vaccines — together with that “no vaccine” is “secure and efficient,” and that “there are other studies out there” exhibiting a connection between vaccines and autism, a hyperlink that has repeatedly been debunked — and claimed falsely that HIV will not be the one explanation for AIDS.
KFF Well being Information discovered that grants in blue states have been disproportionately affected, making up roughly two-thirds of terminated grants, a lot of them at Columbia College. The college had extra grants terminated than all organizations in politically crimson states mixed. On April 4, Democratic attorneys normal in 16 states sued HHS and the NIH to dam the company from canceling funds.
Researchers whose funding was stripped stated they stopped medical trials and different work on bettering take care of individuals with HIV, lowering vaping and smoking charges amongst LGBTQ+ teenagers and younger adults, and rising vaccination charges for younger youngsters. NIH grants routinely span a number of years.
For instance, Hosek stated that when the youth HIV/AIDS community’s funding was terminated, she and her colleagues have been making ready to launch a medical trial inspecting whether or not a specific antibiotic that’s efficient for males to stop sexually transmitted infections would additionally work for ladies.
“It is a critically vital well being initiative centered on younger girls in the USA,” she stated. “With out that examine, girls don’t have entry to one thing that males have.”
Different scientists stated they have been testing learn how to enhance well being outcomes amongst newborns in rural areas with genetic abnormalities, or researching learn how to enhance flu vaccination charges amongst Black youngsters, who’re more likely to be hospitalized and die from the virus than non-Hispanic white youngsters.
“It is vital for individuals to know that — if, , they’re questioning if that is only a waste of money and time. No, no. It was a phenomenal and uncommon factor that we did,” stated Joshua Williams, a pediatric major care physician at Denver Well being in Colorado who was researching whether or not sharing stories about hurt skilled resulting from vaccine-preventable ailments — from missed birthdays to hospitalizations and job loss — may encourage caregivers to get their youngsters vaccinated in opposition to the flu.
He and his colleagues had recruited 200 households, assembled a group advisory board to grasp which vaccinations have been high priorities, created quick movies with individuals who had skilled vaccine-preventable sickness, and texted these movies to half of the caregivers collaborating within the examine.
They have been nearly to crack open the medical information and see if it had labored: Had been the group who obtained the movies extra prone to observe via on vaccinations for his or her youngsters? That’s when he obtained the discover from the NIH.
“It’s the coverage of NIH to not prioritize analysis actions that focuses gaining scientific data on why people are hesitant to be vaccinated and/or discover methods to enhance vaccine curiosity and dedication,” the discover learn.
Williams stated the work was already having an impression as different establishments have been utilizing the concept to start out tasks associated to most cancers and dialysis.
A Hit to Rural Well being
Congress beforehand tried to make sure that NIH grants additionally went to states that traditionally have had much less success acquiring biomedical analysis funding from the federal government. Now these locations aren’t resistant to the NIH’s terminations.
Sophia Newcomer, an affiliate professor of public well being on the College of Montana, stated she had 18 months of labor left on a examine inspecting undervaccination amongst infants, which implies they have been late in receiving really helpful childhood vaccines or didn’t obtain the vaccines in any respect. Newcomer had been analyzing 10 years of CDC information about youngsters’s vaccinations and had already found that almost all U.S. infants from 0 to 19 months outdated weren’t adequately vaccinated.
Her grant was terminated March 10, with the NIH letter stating the mission “now not effectuates company priorities,” a phrase replicated in different termination letters KFF Well being Information has reviewed.
“States like Montana don’t get plenty of funding for well being analysis, and well being researchers in rural areas of the nation are engaged on options to enhance rural well being care,” Newcomer stated. “And so cuts like this actually have an effect on the work we’re capable of do.”
Montana is certainly one of 23 states, together with Puerto Rico, which can be eligible for the NIH’s Institutional Development Award program, meant to bolster NIH funding in states that traditionally have obtained much less funding. Congress established this system in 1993.
The NIH’s grant terminations hit establishments in 15 of these states, greater than half that qualify, plus Puerto Rico.
Researchers Can’t ‘Simply Do It Once more Later’
The NIH’s analysis funds are deeply entrenched within the U.S. well being care system and academia. Hardly ever does an awarded grant keep throughout the 4 partitions of a college that obtained it. One grant’s cash is divvied up amongst different universities, hospitals, group nonprofits, and different authorities businesses, researchers stated.
Erin Kahle, an infectious illness epidemiologist on the College of Michigan, stated she was working with Emory College in Georgia and the CDC as a part of her examine. She was researching the impression of intimate accomplice violence on HIV therapy amongst males dwelling with the virus. “They’re counting on our funds, too,” she stated.
Kahle stated her high precedence was to ethically and safely wind down her nationwide examine, which included 418 individuals, half of whom have been nonetheless collaborating when her grant was terminated in late March. Kahle stated that features offering sources to contributors for whom sharing experiences of intimate accomplice violence could trigger trauma or psychological well being misery.
Rachel Hess, the co-director of the Medical & Translational Science Institute on the College of Utah, stated the College of Nevada-Reno and Intermountain Well being, one of many largest hospital programs within the West, had obtained funds from a $38 million grant that was awarded to the College of Utah and was terminated March 12.
The institute, which goals to make scientific analysis extra environment friendly to hurry up the supply of remedies for sufferers, supported over 5,000 tasks final 12 months, together with 550 medical trials with 7,000 contributors. Hess stated that, for instance, the institute was serving to design a multisite examine involving individuals who have had coronary heart assaults to determine the best combine of medicines “to maintain them alive” earlier than they get to the hospital, a problem that’s extra acute in rural communities.
After pushback from the college — the institute’s tasks included work to scale back well being care disparities between rural and concrete areas — the NIH restored its grant March 29.
Among the many individuals the Utah heart thanked in its announcement concerning the reversal have been the state’s congressional delegation, which consists totally of Republican lawmakers. “We’re grateful to College of Utah management, the College of Utah Board of Trustees, our legislative delegation, and the Utah group for his or her help,” it stated.
Hilliard, of HHS, stated that “some grants have been reinstated following the appeals course of, and the company will proceed to hold out the remaining appeals as deliberate to find out their alignment.” She declined to say what number of had been reinstated, or why the College of Utah grant was amongst them.
Different researchers haven’t had the identical luck. Kahle, in Michigan, stated tasks like hers can take a dozen years from begin to end — making use of for and receiving NIH funds, conducting the analysis, and finishing follow-up work.
“Even when there are modifications within the subsequent administration, we’re at the least a decade of setting again the analysis,” Kahle stated. “It’s not as simple as like, ‘OK, we’ll simply do it once more later.’ It doesn’t actually work that approach.”
Methodology
KFF Well being Information analyzed Nationwide Institutes of Well being grant information to find out the states and organizations most affected by the Trump administration’s cuts.
We tallied the variety of terminated NIH grants utilizing two sources: a Division of Well being and Human Providers checklist of terminated grants printed April 4; and a crowdsourced list maintained by Noam Ross of rOpenSci and Scott Delaney of the Harvard T.H. Chan College of Public Well being, as of April 8. We centered on the primary month of terminations: from Feb. 28 to March 28. We discovered that 780 awards have been terminated in complete, with 770 of them going to recipients primarily based in U.S. states and two to recipients in Puerto Rico.
The evaluation doesn’t account for potential grant reinstatements, which we all know occurred in at the least one occasion.
Further info on the recipients, reminiscent of location and enterprise sort, got here from the USAspending.gov Award Data Archive.
There have been 222 U.S. recipients in complete. No less than 94 of them have been public larger schooling establishments. Forty-one % of organizations that had NIH grants lower within the first month have been in states that President Donald Trump gained within the 2024 election.
Some recipients, together with the College of Texas MD Anderson Most cancers Middle and Vanderbilt College Medical Middle, are medical amenities related to larger schooling establishments. We categorized these as hospitals/medical facilities.
We additionally wished to see whether or not the grant cuts affected states throughout the political spectrum. We usually categorized states as blue if Democrats management the state authorities or Democratic candidates gained them within the final three presidential elections, and crimson in the event that they adopted this sample however for Republicans. Purple states are usually presidential battleground states or these the place voters commonly cut up their help between the 2 events: Arizona, Michigan, Nevada, New Hampshire, North Carolina, Pennsylvania, Virginia, and Wisconsin. The end result was 25 crimson states, 17 blue states, and eight purple states. The District of Columbia was additionally blue.
We discovered that, of affected U.S. establishments, 96 have been in crimson or purple states and 124 have been in blue states.
KFF Well being Information intern Henry Larweh contributed to this report.